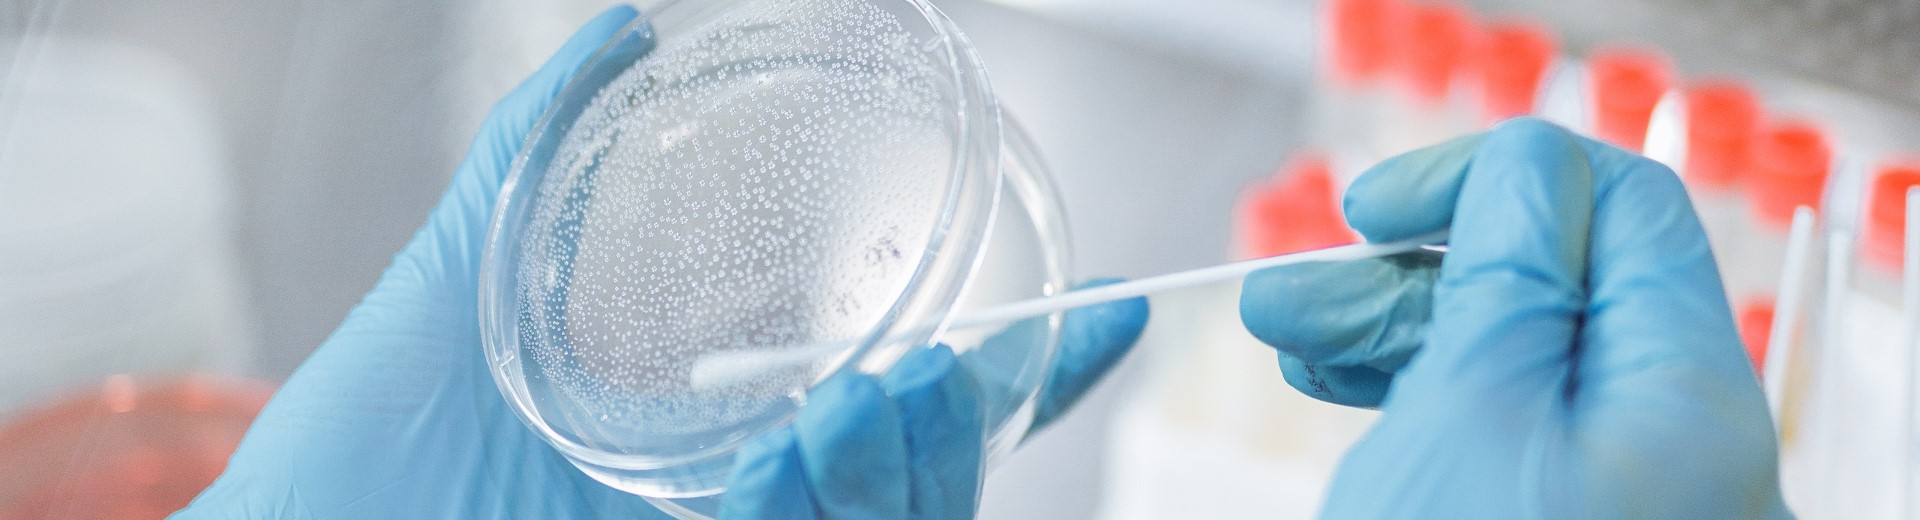
fleexly front page image

Top talents for your decisive projects.
Find Life Sciences freelancers nearby or worldwide.
Life Sciences projects in European countries.
A great place to grow your own freelance business.
Discover freelancers
Use the freelancer search engine to find the most relevant candidates for your project.
Post your needs
Attract freelancers by posting detailed information about your project.
Manage your candidates
Review applications, schedule interviews and hired candidates from one place.
Collaborate easily
Use chat to communicate with freelancers, issue work orders, track project progress and budget with fleexly timesheet.
Complete your profile
Tell us about you and fleexly connects you with the best companies' project.
Companies come to you
Once your resume is published, companies see it immediately and will contact you quickly.
Explore Projects
Use filters to find and apply to projects in your domain.
Collaborate easily
Use chat to communicate with companies, share your project progress and budget consumption with fleexly timesheet.
A one-stop marketplace and a new collaboration model addressing all challenges faced by freelancers and companies.
A fast, simple and cost-effective online talent solution for companies and freelancers of life sciences sectors.
The fleexly story begins over a year ago, when the two founders realized that SMEs of the pharma, biotech and medtech industry were struggling with finding easily and quickly skilled resources for their decisive projects.
At the same time, a multitude of brilliant and passionate freelancers are looking for thrilling projects, while focusing on their freelance network expansion.
A new way of collaborating is born
In response, the founders created a new web-based platform that brings visibility to projects and trust to freelancers work.
Together they decided to start a company, fleexly, that would deliver a new piece of technology : a unique online talent platform for companies and freelancers of the pharma, biotech and medtech industry.
This sourcing platform gives to companies a reliable access to a large pool of quality professionals, while freelancers enjoy freedom and flexibility to find great projects online.
A world of opportunities
fleexly makes it fast, simple and cost-effective to find, connect to, work with, and pay the best professionals in the industry. All fleexly freelancers are experts in their field and are committed to make the difference in your decisive projects.
Our vision
Creating collaboration opportunities to foster innovation so patients have better health conditions.
Our mission
Connecting talented people and companies with great ambitions to work together with passion.
Our values
Make things fast and simple.
Promote trust while fostering growth.
Inspire an innovative future of work.